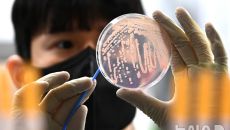

2026
일
월
화
수
목
금
토
-

'롤러 코스닥'…어제는 14% 급락 오늘은 14% 급등
코스닥 14.1%·코스피 9.63% 급등…양 시장 매수 사이드카 코스닥 외국인·기관 매수…개인은 코스닥→코스피로 이동 미 증시- 18시간전
- 비즈워치
-

강원문화재단, 청년예술인 교육이음 '2차 공모'
[고정화 기자] (강원=국제뉴스) 고정화 기자 = 강원문화재단(대표 신현상)은 '2026년 청년예술인 교육이음 사업' 2차 공- 18시간전
- 국제뉴스
-

닥터애그, 스마트팜·콜드체인 기반으로 연매출 1,000억 달성…글로벌 확장 본격화
황소고집 팽이버섯 브랜드로 잘 알려진 스마트팜 농업회사법인 닥터애그(대표 김진석)가 2025년 연매출 1,000억 원을 기록했- 18시간전
- 동아일보
-

우즈, 데뷔 13년만 첫 정규 통했다..‘Archive. 1’ 전곡 차트인
[OSEN=김채연 기자] 가수 우즈(WOODZ, 조승연)가 데뷔 13년 만에 발매한 첫 정규 앨범으로 음원 차트에서 존재감을- 18시간전
- OSEN
-
식중독 증세 '쉬쉬' 충주 기업체에 250만원 과태료
[충주=뉴시스] 이병찬 기자 = 충북 충주시는 집단 식중독 의심 증세가 발생했는데도 이를 당국에 신고하지 않은 지역 소재 대기- 18시간전
- 뉴시스
-

‘왕과 사는 남자’ 천만 눈앞…윤종신 “장항준, 지금 행운 과한 듯”
아시아투데이 정아름 기자 = 가수 윤종신이 장항준 감독과의 과거 일화를 공개했다. 지난 4일 공개된 tvN 예능 프로그램 '유- 18시간전
- 아시아투데이
-

한섬 더캐시미어, 2026 'CLUB 15' 캠페인 공개
[피보웅 기자] (서울=국제뉴스) 피보웅 기자 = 현대백화점그룹 한섬(대표 김민덕)의 프리미엄 브랜드 더캐시미어(theCASH- 18시간전
- 국제뉴스
-

한전, S&P 글로벌 '지속가능성 평가' 우수기업 선정
한국전력이 세계 최고 권위의 지속가능성 평가에서 우수 기업으로 선정되며 글로벌 수준의 ESG 경영 성과를 대외적으로 인정받았다- 18시간전
- 이투데이
-

[증시 긴급진단] “코스피 7200까지…반도체가 중동 리스크 뚫고 'W자 반등' 이끈다”
최근 국내 증시가 기록적인 변동성을 보이고 있다. 전날 4일 코스피가 12% 폭락에 이어 5일에는 10% 가까이 폭등하며 ‘매- 18시간전
- 세계비즈
-

타이탄글로벌 亞법인 아일라 "유틸리티 토큰 시대 열겠다"
타이탄글로벌(Titan Global)의 아시아 법인 아일라는 결제 화면에서 실력을 증명하는 유틸리티 토큰의 시대 열어갈 것이라- 18시간전
- 팍스경제TV
-

울산 남구, 안심귀가앱 기능 강화…위급시 사진 자동전송·대응
(울산=연합뉴스) 김용태 기자 = 울산시 남구는 안심귀가 서비스 앱을 개편해 이용자의 편의성과 긴급 대응 기능을 강화했다고 5- 18시간전
- 연합뉴스
-

카카오TV, 오는 6월 서비스 종료된다
[서울경제TV=최연두기자] 카카오의 동영상 플랫폼 ‘카카오TV’가 오는 6월30일 서비스를 종료한다. 2017년 서비스를 시작- 18시간전
- 서울경제TV
-

순창군의회, 신광주-신임실 송전선로 노선 결정 철회 촉구
[서울경제TV 전북=최영 기자] 전북 순창군의회가 한국전력이 추진 중인 신광주-신임실 송전선로 노선 결정과 관련해 절차적 정당- 18시간전
- 서울경제TV
-
김문수 '공직선거법 위반' 1심 이르면 다음 달 마무리
21대 대통령 선거 과정에서 국민의힘 예비 후보 신분으로 유권자에게 명함을 돌린 혐의로 기소된 김문수 전 고용노동부 장관의 재판이 이르면 다음 달 마무리- 18시간전
- YTN
-

'사별' 정선희, 생애 첫 결심... "포기 못 한다" ('집 나간 정선희')
(MHN 홍지현 기자) 코미디언 정선희가 인생 첫 퍼스널 컬러 진단에 나섰다. 지난 4일 채널 '집 나간 정선희'에는 '정선희- 18시간전
- MHN스포츠

